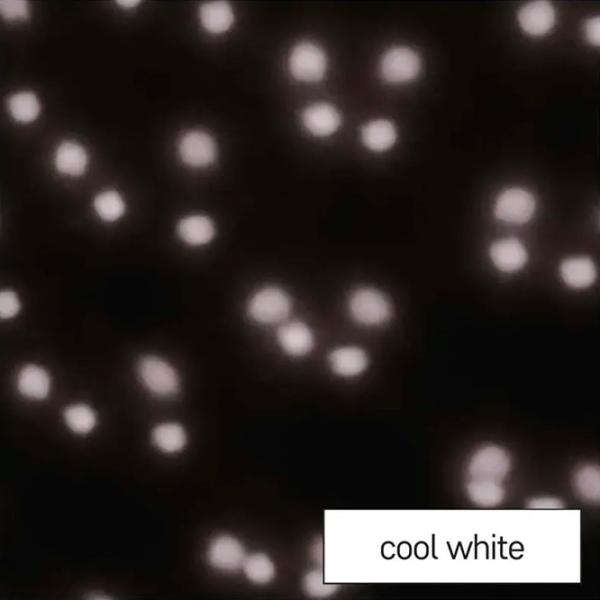

Livrare gratuită de la 1000 lei
Comenzi până la 1000 lei - Livrare 50 lei
Orarul livrărilor
Luni – Sâmbătă 10:00 - 19:00
Duminică 9:00 - 18:00
Livrare gratuită de la 1500 lei
Comenzi până la 1500 lei - Livrare 100 lei
Orarul livrărilor
Luni - Sâmbătă 9:00 - 18:00
* Cu excepția produselor la comandă sau a comenzilor de la furnizor, în conformitate cu graficul de livrare
Gratuit – livrăm orice tip de produs la orice etaj.
Gratuit – livrăm în apartament sau în locul specificat.
Gratuit – scoatem tehnica veche. Programul eUpgrade.
Ai posibilitatea de a achita curierului cu cardul, numerar sau să semnezi contractul de împrumut. Se verifică complet tehnica, o eventuală lipsă sau deteriorare. Se oferă o scurtă instrucțiune privind conectarea.
* Excepție face livrarea prin serviciul „Nova Poșta”.
| Model | Fulgi în mișcare |
| Brand | EMOS |
| Puterea | 4 W |
| Temperatura culorii | 6500 K |
| Forma | Rotundă |
| Categorie | Proiector LED |
| Cod model | DCPC03 |
| Culoarea de bază | Black |
| Culoarea de iluminare | White |
| Materialul cadrului | Plastic |
| Material abajur | Plastic |
| Lungime cablu | 3 m |
| Specificaţii | 220 - 240 V |
| Grad de protecție | IP44 |